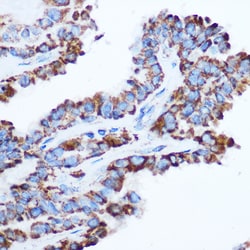
Invitrogen PDHA1 Polyclonal Antibody 100 &mu;L; Unconjugated:Antibodies,

Learn More
Invitrogen™ PDHA1 Polyclonal Antibody


Rabbit Polyclonal Antibody
Brand: Invitrogen™ PA595980
Description
Immunogen sequence: FANDATFEIK KCDLHRLEEG PPVTTVLTRE DGLKYYRMMQ TVRRMELKAD QLYKQKIIRG FCHLCDGQEA CCVGLEAGIN PTDHLITAYR AHGFTFTRGL SVREILAELT GRKGGCAKGK GGSMHMYAKN FYGGNGIVGA QVPLGAGIAL ACKYNGKDEV CLTLYGDGAA NQGQIFEAYN MAALWKLPCI FICENNRYGM GTSVERAAAS TDYYKRGDFI PGLRVDGMDI LCVREATRFA AAYCRSGKGP ILMELQTYRY HGHSMSDPGV SYRTREEIQE VRSKSDPIML LKDRMVNSNL ASVEELKEID VEVRKEIEDA AQFATADPEP PLEELGYHIY SSDPPFEVRG ANQWIKFKSV S; Positive Samples: Mouse heart, Mouse skeletal muscle; Cellular Location: Mitochondrion matrix.
The pyruvate dehydrogenase (PDH) complex is a nuclear-encoded mitochondrial multienzyme complex that catalyzes the overall conversion of pyruvate to acetyl-CoA and CO(2), and provides the primary link between glycolysis and the tricarboxylic acid (TCA) cycle. The PDH complex is composed of multiple copies of three enzymatic components: pyruvate dehydrogenase (E1), dihydrolipoamide acetyltransferase (E2) and lipoamide dehydrogenase (E3). The E1 enzyme is a heterotetramer of two alpha and two beta subunits. This gene encodes the E1 alpha 1 subunit containing the E1 active site, and plays a key role in the function of the PDH complex. Mutations in this gene are associated with pyruvate dehydrogenase E1-alpha deficiency and X-linked Leigh syndrome. Alternatively spliced transcript variants encoding different isoforms have been found for this gene.
Specifications
| PDHA1 | |
| Polyclonal | |
| Unconjugated | |
| PDHA1 | |
| PDHA; PDHA1; Pdha-1; PDHAD; PDHCE1A; PDHE1-A type I; PHE1A; pyruvate dehydrogenase; pyruvate dehydrogenase (lipoamide) alpha 1; pyruvate dehydrogenase alpha 1; pyruvate dehydrogenase complex, E1-alpha polypeptide 1; pyruvate dehydrogenase E1 alpha 1; pyruvate dehydrogenase E1 alpha 1 subunit; pyruvate dehydrogenase E1 component alpha subunit; pyruvate dehydrogenase E1 component alpha subunit precursor; pyruvate dehydrogenase E1 component subunit alpha, somatic form, mitochondrial; pyruvate dehydrogenase E1 subunit; pyruvate dehydrogenase E1 subunit alpha 1; pyruvate dehydrogenase E1alpha subunit | |
| Rabbit | |
| Affinity chromatography | |
| RUO | |
| 18597, 29554, 5160 | |
| -20°C, Avoid Freeze/Thaw Cycles | |
| Liquid |
| ELISA, Immunohistochemistry (Paraffin), Immunoprecipitation, Western Blot, Immunocytochemistry | |
| 0.96 mg/mL | |
| PBS with 50% glycerol and 0.09% sodium azide; pH 7.3 | |
| P08559, P26284, P35486 | |
| PDHA1 | |
| Recombinant fusion protein containing a sequence corresponding to amino acids 30-390 of human PDHA1 (NP_0002751). | |
| 100 μL | |
| Primary | |
| Human, Mouse, Rat | |
| Antibody | |
| IgG |
Your input is important to us. Please complete this form to provide feedback related to the content on this product.